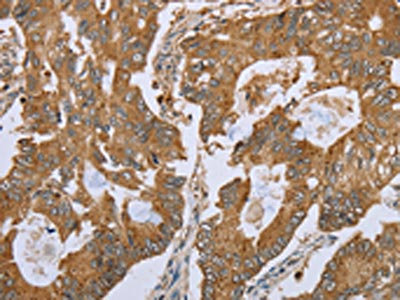

-
中文名稱:NLRP10兔多克隆抗體
-
貨號:CSB-PA207849
-
規格:¥1100
-
圖片:
-
The image on the left is immunohistochemistry of paraffin-embedded Human colon cancer tissue using CSB-PA207849(NLRP10 Antibody) at dilution 1/45, on the right is treated with synthetic peptide. (Original magnification: ×200)
-
The image on the left is immunohistochemistry of paraffin-embedded Human gastric cancer tissue using CSB-PA207849(NLRP10 Antibody) at dilution 1/45, on the right is treated with synthetic peptide. (Original magnification: ×200)
-
-
其他:
產品詳情
-
Uniprot No.:
-
基因名:
-
別名:CLR11.1 antibody; NACHT, leucine rich repeat and PYD containing 10 antibody; NACHT, LRR and PYD domains containing protein 10 antibody; NACHT, LRR and PYD domains-containing protein 10 antibody; NAL10_HUMAN antibody; NALP10 antibody; NLR family, pyrin domain containing 10 antibody; Nlrp10 antibody; NOD8 antibody; Nucleotide-binding oligomerization domain protein 8 antibody; Nucleotide-binding oligomerization domain, leucine rich repeat and pyrin domain containing 10 antibody; PAN5 antibody; PYNOD antibody
-
宿主:Rabbit
-
反應種屬:Human
-
免疫原:Synthetic peptide of Human NLRP10
-
免疫原種屬:Homo sapiens (Human)
-
標記方式:Non-conjugated
-
抗體亞型:IgG
-
純化方式:Antigen affinity purification
-
濃度:It differs from different batches. Please contact us to confirm it.
-
保存緩沖液:-20°C, pH7.4 PBS, 0.05% NaN3, 40% Glycerol
-
產品提供形式:Liquid
-
應用范圍:ELISA,IHC
-
推薦稀釋比:
Application Recommended Dilution ELISA 1:2000-1:5000 IHC 1:50-1:200 -
Protocols:
-
儲存條件:Upon receipt, store at -20°C or -80°C. Avoid repeated freeze.
-
貨期:Basically, we can dispatch the products out in 1-3 working days after receiving your orders. Delivery time maybe differs from different purchasing way or location, please kindly consult your local distributors for specific delivery time.
-
用途:For Research Use Only. Not for use in diagnostic or therapeutic procedures.
相關產品
靶點詳情
-
功能:Inhibits autoprocessing of CASP1, CASP1-dependent IL1B secretion, PYCARD aggregation and PYCARD-mediated apoptosis but not apoptosis induced by FAS or BID. Displays anti-inflammatory activity. Required for immunity against C.albicans infection. Involved in the innate immune response by contributing to proinflammatory cytokine release in response to invasive bacterial infection. Contributes to T-cell-mediated inflammatory responses in the skin. Plays a role in protection against periodontitis through its involvement in induction of IL1A via ERK activation in oral epithelial cells infected with periodontal pathogens. Exhibits both ATPase and GTPase activities.
-
基因功能參考文獻:
- Authors observed an important role of NLRP10 in cytokine and chemokine production as well as expression of NF-kappaB and MAPKs in CSE-exposed A549 cells. Furthermore, replenishment of A549 cell culture with recombinant IL-17A (rIL-17A) during NLRP10 knockdown rescued CSE-induced inflammatory responses. PMID: 29501574
- these data suggest that NLRP10 is involved in activating the ERK signalling pathway in oral epithelial cell line infected with Tannerella forsythia and Fusobacterium nucleatum PMID: 28766990
- Review summarize recent advances of the role of of human and murine NLRP10 in innate and adaptive immune responses. [Review] PMID: 23562614
- These data revealed a novel role of NLRP10 in innate immune responses towards bacterial infection and suggest that NLRP10 functions as a scaffold for the formation of the NOD1-Nodosome. PMID: 22672233
- The results show that either deletion of the p53 binding elements within the PYNOD promoter or treatment with p53 inhibitor could significantly reduce PYNOD promoter activity. PMID: 22365966
- Transgenic PYNOD colocalizes with apoptosis-associated speck-like protein containing a caspase recruitment domain (ASC) and inhibits caspase-1-mediated interleukin (IL)-1beta processing without inhibiting caspase-4-mediated caspase-1 processing. PMID: 20393137
- Observational study of gene-disease association. (HuGE Navigator) PMID: 20403135
- PYNOD is a novel regulator of apoptosis and inflammation. PMID: 15096476
- PYPAF3 is a feedback regulator of interleukin-1beta secretion, and PYPAF2 and PYPAF3, together with PYNOD, constitute an anti-inflammatory subgroup of PYRIN-containing apoptotic protease-activating factor-1-like proteins PMID: 15817483
- The structural modification of the NLRP10 gene might have played a role in development or enhancement of human-specific traits during evolution. PMID: 19544093
顯示更多
收起更多
-
亞細胞定位:Cytoplasm. Cell membrane; Peripheral membrane protein.
-
蛋白家族:NLRP family
-
組織特異性:Highly expressed in basal and suprabasal epidermal cell layers with lower levels in dermal fibroblast cells (at protein level). Widely expressed with highest levels in heart, brain and skeletal muscle. Also expressed in liver, colon, dermis and epidermis.
-
數據庫鏈接:
Most popular with customers
-
-
YWHAB Recombinant Monoclonal Antibody
Applications: ELISA, WB, IHC, IF, FC
Species Reactivity: Human, Mouse, Rat
-
Phospho-YAP1 (S127) Recombinant Monoclonal Antibody
Applications: ELISA, WB, IHC
Species Reactivity: Human
-
-
-
-
-